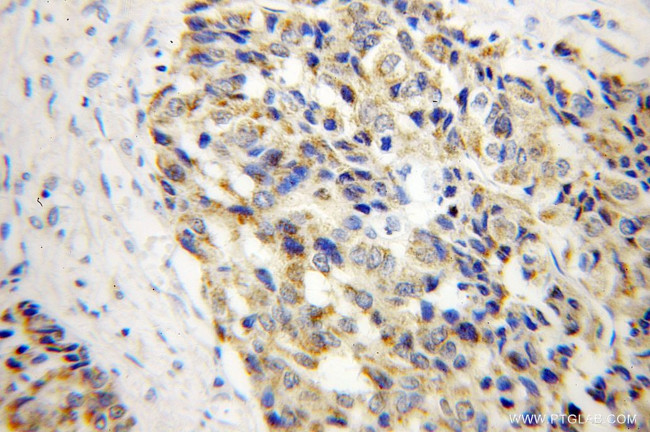
MTHFS Antibody in Immunohistochemistry (Paraffin) (IHC (P))

Search
Proteintech
MTHFS Polyclonal Antibody
{{$productOrderCtrl.translations['antibody.pdp.commerceCard.promotion.promotions']}}
{{$productOrderCtrl.translations['antibody.pdp.commerceCard.promotion.viewpromo']}}
{{$productOrderCtrl.translations['antibody.pdp.commerceCard.promotion.promocode']}}: {{promo.promoCode}} {{promo.promoTitle}} {{promo.promoDescription}}. {{$productOrderCtrl.translations['antibody.pdp.commerceCard.promotion.learnmore']}}
产品信息
13114-1-AP
种属反应
宿主/亚型
分类
类型
抗原
偶联物
形式
浓度
规格
纯化类型
保存液
内含物
保存条件
运输条件
产品详细信息
Immunogen sequence: MAAAAVSSA KRSLRGELKQ RLRAMSAEER LRQSRVLSQK VIAHSEYQKS KRISIFLSMQ DEIETEEIIK DIFQRGKICF IPRYRFQSNH MDMVRIESPE EISLLPKTSW NIPQPGEGDV REEALSTGGL DLIFMPGLGF DKHGNRLGRG KGYYDAYLKR CLQHQEVKPY TLALAFKEQI CLQVPVNEND MKVDEVLYED SSTA (1-203 aa encoded by BC019921)
靶标信息
Contributes to tetrahydrofolate metabolism. Helps regulate carbon flow through the folate-dependent one-carbon metabolic network that supplies carbon for the biosynthesis of purines, thymidine and amino acids.
仅用于科研。不用于诊断过程。未经明确授权不得转售。
篇参考文献 (0)
生物信息学
蛋白别名: 5, 10-methenyltetrahydrofolate synthetase; 5,10-methenyl-tetrahydrofolate synthetase; 5,10-methenyltetrahydrofolate synthetase (5-formyltetrahydrofolate cyclo-ligase); 5-formyltetrahydrofolate cyclo-ligase; FLJ30410; methenyl-THF synthetase; MTHFS
基因别名: 1110034I12Rik; 2310020H23Rik; AI119695; HsT19268; MTHFS; NEDMEHM
UniProt ID: (Human) P49914, (Mouse) Q9D110
Entrez Gene ID: (Human) 10588, (Rat) 300886, (Mouse) 107885